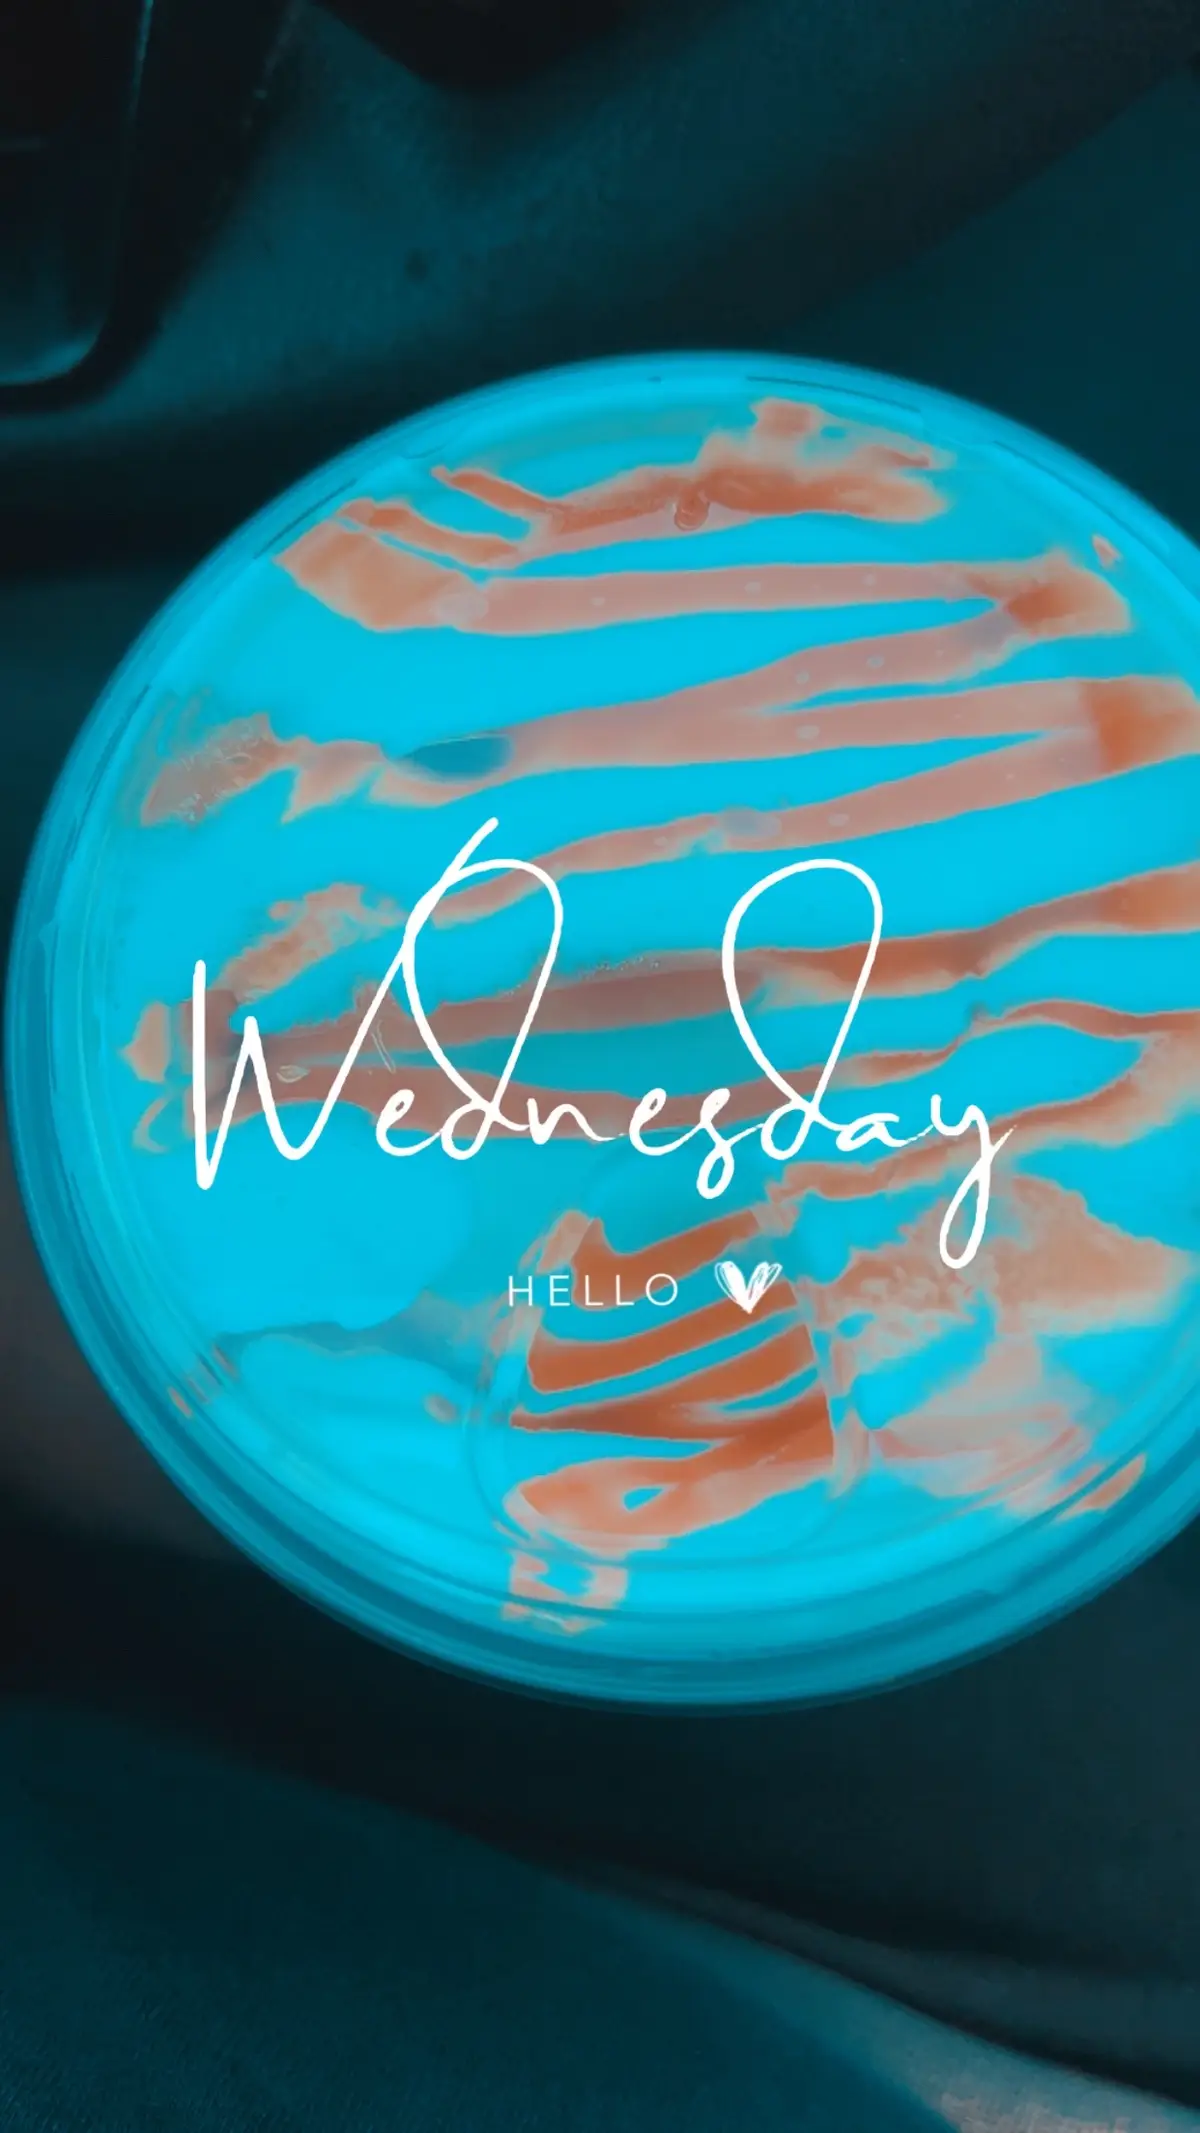

david 🙌
Region: CO
Thursday 18 September 2025 20:23:12 GMT
473
67
1
3
Music
Download
Comments
Nuga heartbeatcreature :
beautiful soul 🤲pure heart ❤️JESUS CHRIST BLESS YOU IN EVERY STEP OF YOUR LIFE BECAUSE HE IS OUR SAVIOUR 🙏
2025-09-19 05:23:43
1
To see more videos from user @paratiii902, please go to the Tikwm
homepage.